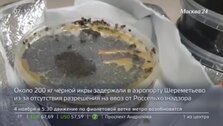

25 октября 2017, 07:30
Общество"Утро": погода на неделю в столичном регионе
Сегодня столица останется во власти антициклона с характерной для него спокойной и преимущественно сухой погодой. Температура воздуха по-прежнему сохраняется ниже климатической нормы. Она не поднимается выше 1 градуса тепла. Ветер юго-западный. Скорость потоков – 2 метра в секунду. Ночью похолодает до -3 градусов. Атмосферное давление будет меняться мало и составит 760 миллиметров ртутного столба, что на 14-16 миллиметров выше нормы. Метеозависимым людям сегодня и завтра нужно быть осторожнее .
В четверг в Москву придет циклон. Надвигаясь с запада, он принесет в город обширные облачные поля и небольшой снег. Днем температура воздуха будет около ноля. Ветер юго-восточный со скоростью 7 метров в секунду. Атмосферное давление будет падать, составив 752 миллиметра ртутного столба.
В пятницу столица окажется в теплом секторе циклона. Возрастет вероятность осадков, и немного потеплеет. Днем столбики термометров снова покажут 1 градус выше ноля.
В первый выходной день город по-прежнему останется во власти циклона. Вновь ожидаются осадки, будет ветрено. Температурный фон будет на 1-2 градуса ниже климатической нормы. Днем – 2 градуса тепла.
Воскресенье не порадует жителей столицы улучшением погоды. По-прежнему будет пасмурно, ветрено и холодно. Днем все те же 2 градуса выше ноля. Подробнее – в сюжете телеканала Москва 24.







Собянин: в районе Богородское построили школу на 600 мест